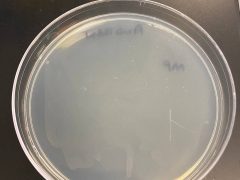
MP-Plate
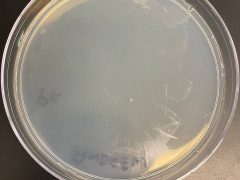
Px-Plate

Description
I collected this soil sample near a bayou to see if the soil near the bayou contained organophosphorus degrading bacteria which would indicate that pesticides were being used on land areas that are upstream/downstream from the nearby water source (brays bayou) mentioned above. The soil collected was also quite dry in texture and appearance.
Data for Soil Sample and Researcher
Location of Soil Sample
3802 Singing Coast Path, Houston, TX 77082, USA, 3802 Singing Coast Path, Houston, Texas 77082, United States, 29.716437, -95.649449
Collection Date of Soil Sample
Researcher
Andrew Carrillo
Organization
University of Houston
Lab Day
Monday
Time of Lab
4:00 PM
Course Term
Summer
Year of Course
2024
Image Descriptions in General
Each photo represents a photo where each minimal media culture tube’s image was taken after 1 week of 37°C incubation. The last two photos are of the overgrowth observed on the streaked MP and Px plates.
Extended Analysis Results
Cataloged
No